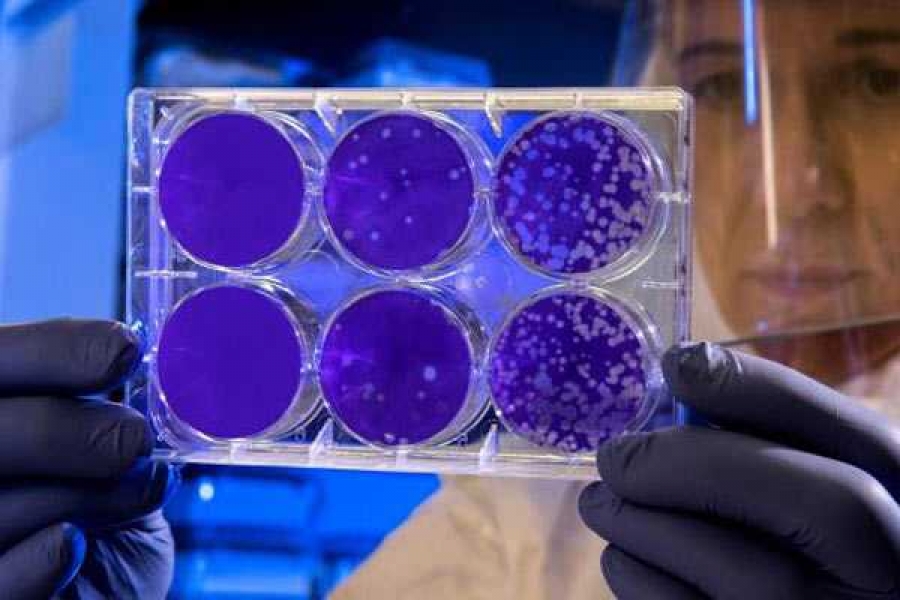
Фото: unsplash.com

Больных в Китае становится все больше.
Число больных новым коронавирусом в Китае приближается к 1000
26.01.2020
Фото: unsplash.com
Как сообщает ФедералПресс, в Китае выросло количество больных пневмонией. Число жертв новой болезни приближается к 1000.
Увеличилось количество подтвержденных больных новым типом коронавируса в Китае. Количество людей, которые подхватили вирус, стремительно приближается к 1000. Сегодня в Пекине диагноз поставили еще 36 людям.
В общей сложности в Китае насчитывается 900 больных. Они есть во всех областях республики, кроме Тибетского района. В 13 городах страны власти приостановили транспортное сообщение. Это делается для контроля за распространением вируса.
Немного ранее сегодня поступала информация только о 877 зараженных. От пневмонии погибли уже как минимум 26 человек.
Из-за быстрого распространения болезни высший уровень реагирования объявили в крупнейших городах КНР – Пекине и Шанхае. В них живут 22 и 24 миллиона человек соответственно.+
Также мера коснулась всей провинции Хубэй с населением 59,2 миллиона человек. Там располагается город Ухань, с которого началась вспышка болезни, пишет ТАСС.
Вчера врачи назвали еще один возможный первоисточник заражения коронавирусом. Первыми заболеть могли люди, которые ели змей.
Последние новости
30.04.2026
30.04.2026
30.04.2026
30.04.2026







Комментарии 0